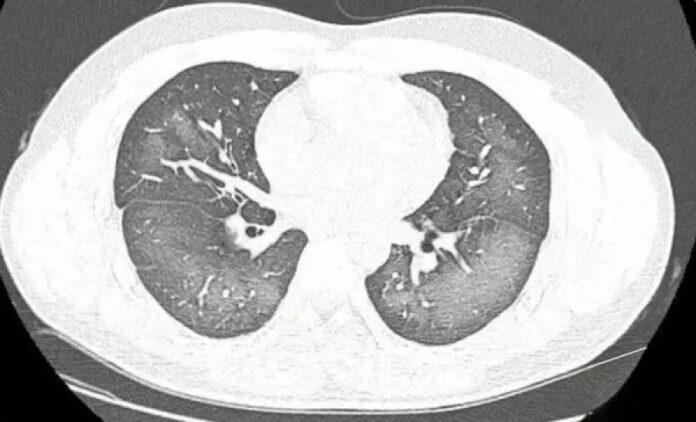
d812da679edeb749e41b26ff4596aa32

(长沙8日讯)除了使用雨伞和戴帽子,许多人在防晒时还会使用防晒霜或防晒喷雾。近日,一名年轻男子在使用防晒喷雾时不慎吸入,导致出现胸闷、咳嗽等症状,后来在医院就诊时被查出患有“白肺”。
Advertisement
据报道,这名年轻男子李林(化名),现年20岁。他不久前在外出前使用了防晒喷雾,但在喷洒过程中误吸了一些。随后,他开始感到胸闷和咳嗽,这种症状一直持续到第二天都没有好转。
他赶紧前往湖南省长沙市第三医院就诊。在进行肺部CT检查时,医生惊讶地发现李林的双肺出现了广泛的白色病变,检查报告甚至显示了“白肺”。
据了解,“白肺”通常指的是在X光或CT检查中显示出的重度肺部炎症。患者的肺部会呈现大片白色病变,常伴随呼吸困难和呼吸衰竭,极端情况下可能导致其他器官功能障碍。
值得注意的是,“白肺”通常出现在年长者(65岁以上)以及免疫力较低、有重要器官慢性疾病史(如心脏病、中风、慢性肾脏病、慢性阻塞性肺疾病等)的人群中。然而,这次的案例发生在年轻且一直身体健康的李林身上,显得异常罕见。
长沙市第三医院放射影像科医生指出,“白肺”的成因除了感染和弥漫性肺泡出血综合症等,吸入有害物质如粉尘、喷雾等也可能导致肺部出现广泛的白色病变。
李林之所以患上“白肺”,正是因为使用防晒产品时不当,导致部分产品进入肺部,从而引发了严重的后果。
幸运的是,在接受医生治疗后,李林的症状得到了明显改善,情况逐渐稳定。但这次事故也提醒所有人,无论年龄,使用防晒产品时都必须小心谨慎,避免误吸或引发其他潜在风险。
在使用防晒喷雾时,应当注意适量原则,尽量遮住口鼻,不建议直接对着脸部喷洒。最好是将防晒产品喷在手掌上,然后均匀涂抹在脸上。如果使用防晒产品后出现过敏或其他身体不适,应立即停止使用并及时就医。